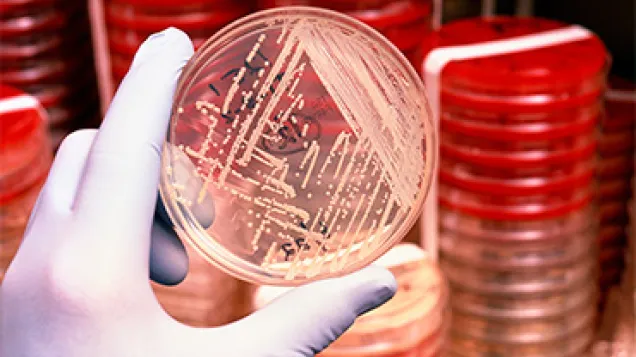
Antibiotic resistant bacteria. © Science Photo Library

European Surveillance of Antimicrobial Consumption Network (ESAC-Net)
ESAC-Net (formerly ESAC) is a Europe-wide network of national surveillance systems, providing European reference data on antimicrobial consumption. ESAC-Net collects and analyses data on antimicrobial consumption from EU and EEA countries, both in the community and in the hospital sector.
The collected data are used to provide timely information and feedback to EU and EEA countries on indicators of antimicrobial consumption. These indicators provide a basis for monitoring the progress of EU and EEA countries towards prudent use of antimicrobials.
The coordination of ESAC-Net was transferred from the University of Antwerp, Belgium to the European Centre for Disease Prevention and Control in July 2011.
Contact
For inquiries on ESAC-Net and its website, please contact the ESAC-Net contact persons at the European Centre for Disease Prevention and Control (ECDC). In case of technical problems or for any inquiries/feedback about the ESAC-Net interactive database, please contact the TESSy Helpdesk.
- Email ESAC-Net on ESAC-Net
 ecdc [dot] europa [dot] eu (ESAC-Net[at]ecdc[dot]europa[dot]eu)
ecdc [dot] europa [dot] eu (ESAC-Net[at]ecdc[dot]europa[dot]eu) - Email TESSy team on TESSy
 ecdc [dot] europa [dot] eu (TESSy[at]ecdc[dot]europa[dot]eu)
ecdc [dot] europa [dot] eu (TESSy[at]ecdc[dot]europa[dot]eu)
The network continues collecting reference data on the consumption of antimicrobials for systemic use in the community and in the hospital sector in EU and EEA/EFTA countries through the European Surveillance System (TESSy).
ESAC-Net reporting protocol for antimicrobial consumption (AMC) surveillance data.
Published reports and data...
Organisation
ESAC-Net management and coordination: ESAC-Net is managed and coordinated by ECDC and supported by a Coordination Group composed of experts selected among the nominated ESAC-Net contact points.
National institutions/organisations participating in ESAC-Net
| Country | National institutes/organisations | Website |
|---|---|---|
| Austria | Ministry of Health | www.bmg.gv.at/ |
| Belgium | Public Health, Food Chain Safety and Environment Scientific Institute of Public Health University of Antwerp (Laboratory of Medical Microbiology) National Institute for Health and Disability Insurance (INAMI-RIZIV) |
www.health.belgium.be www.wiv-isp.be https://www.inami.fgov.be/fr/Pages/default.aspx |
| Bulgaria | National Centre of Infectious and Parasitic DiseasesAlexander University Hospital, Medical University | www.ncipd.org |
| Croatia | Croatian Academy of Medical SciencesInterdisciplinary Section for Antibiotic Resistance Control (ISKRA), Ministry of Health | www.Iskra.bfm.hr |
| Cyprus | Directorate of Medical and Public Health ServicesPharmaceutical Services | www.moh.gov.cy |
| Czech Republic | Charles University, Faculty of pharmacy | www.faf.cuni.cz |
| Denmark | Statens Serum Institut | www.ssi.dk |
| Estonia | Health BoardState Agency of Medicines | www.terviseamet.ee www.ravimiamet.ee |
| Finland | National Institute for Health and Welfare | www.thl.fi |
| France | National Institute for Public Health SurveillanceAgency for the Safety of Health Products | www.ansm.sante.fr/ |
| Germany | Robert Koch Institute Wissenschaftliches Institut der AOK (WIdO) | www.rki.de www.wido.de |
| Greece | Hellenic Centre for Disease Control and Prevention National Organization for Medicines |
www.eof.gr |
| Hungary | National Centre for Epidemiology University of Szeged | www.oek.hu www.u-szeged.hu |
| Iceland | Centre of Health Security and Communicable Disease Control | www.landlaeknir.is/ www.lyfjastofnun.is/ |
| Ireland | Health Protection Surveillance Centre | www.hpsc.ie |
| Italy | Ministry of Health National Institute of Health Italian Medicines Agency | http://www.salute.gov.it |
| Latvia | The Centre for Disease Prevention and Control (CDPC) of Latvia State Agency of Medicines of Latvia |
www.spkc.gov.lv https://www.zva.gov.lv/en |
| Lithuania | Institute of Hygiene | www.hi.lt |
| Malta | National Antibiotic Committee | Health (gov.mt) |
| Netherlands | National Institute for Public Health and the Environment Dutch working group on antibiotic policy | www.rivm.nl www.swab.nl |
| Norway | Norwegian Institute of Public Health | www.fhi.no |
| Poland | National Medicines Institute, Department of Epidemiology and Clinical Microbiology | www.nil.gov.pl |
| Portugal | National Authority of Medicines and Health Products | www.infarmed.pt |
| Romania | National Institute of Public Health | |
| Slovakia | Comenius University | www.uniba.sk |
| Slovenia | National Institute of Public Health University Medical Centre Ljubljana |
https://www.nijz.si/en https://www.kclj.si/ |
| Spain | National Centres of Microbiology and Epidemiology Spanish Agency of Medicines and Medical Devices (AEMPS) University Hospital Son Espases University Hospital of Bellvitge |
www.aemps.gob.es www.bellvitgehospital.cat |
| Sweden | Public Health Agency of Sweden | http://www.folkhalsomyndigheten.se/ |